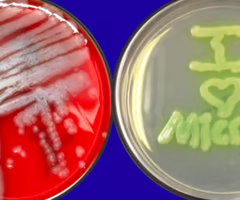
<p>Identify the pathogen?</p>

1/36
Looks like no tags are added yet.
Name | Mastery | Learn | Test | Matching | Spaced | Call with Kai |
|---|
No analytics yet
Send a link to your students to track their progress
Enterobacteriaceae will include what bacteria?
Proteus
Klebsiella
Enterobacter
What are characteristics of Enterobacteriaceae?
Gram -
Straight rods, ferment glucose (acid/ gas production)
Facultative anaerobes
What agar will enterobacteriaceae grow on?
Blood MacConkey agar
Which two enterobacteriaceae will be motile?
Proteus
Enterobacter
(Kleb- NOT motile)
What enterobacteriaceae will ferment lactose?
Klebsiella enterobacter
What enterobacteriaceae will produce urease?
Protus Klebsiella
What enterobacteriaceae will produce H2S on a TSI slant?
Proteus
What virulence factor will enterobacteriaceae all share?
LPS - endotoxins that are exposed causing toxic shock after cell is lysed.
Virulence factors of Proteus?
Urease (change urine pH)
Fimbrae - colonization
Hemolysin - pore forming - dissimination from bladder to kidney.
How can you tx Proteus mirabilis?
(B - lactams) Amoxicillin, Ampicillin, Clavamox, Ceftiofur.
What are virulence factors of Klebsiella?
Capsule
Endotoxin
Adhesion
Cytotoxic toxin (can have shiga toxin)
All enterobacteriaceae can cause what dz in dogs?
UTI
Both Enterobacter aerogenes and Klebsiella pneumonia can cause what in cattle?
Coliform mastitis
What can Proteus mirabilis and vulgaris cause in dogs and cats?
Otitis externa
What is the quantitative urine culture needed to confirm UTI?
More than 100,000 cfu/mL
Enterobacteriaceae will be Oxidase _ and Catalase _?
Negative
Positive
Which enterobacteriaceae will be yellow when grown on MacConkey agar and won’t have mucoid colonies?
Proteus - yellow (rest are pink)
What kind of culture should be done for samples thought to have enterobacteriaceae?
Aerobic culture and sensitivity
What do you do to tx Klebsiella pneumonia?
Aminoglycosides (resistant to Ampicillin)
What is used to tx Enterobacter aerogenes?
Aminoglycosides
B-lactams
Cephalosporins
What are characteristics of Pseudomonas?
Gram neg
Straight slender bacilli
Motile - flagellated
Obligate anaerobe
Pseudomonas will be Oxidase and Catalase _ ?
Positive (for both)
What type of Pseudomonas will be most clinically relevant in vet med?
Pseudomonas aeruginosa
What are the 4 possible pigments of Pseudomonas and what colors are they?
Pyocyanin- blue
Pyoverdin - yellow/green fluroescent
Pyorubin - red
Pyomelanin - Brown
What do Pseudomonas eat?
Carbon compounds
Electric donors for energy.
Pseudomonas is an __ Pathogen?
Opportunistic - wounds or immunosuppression
Virulence factors of Pseudomonas? (9)
Capsule
Cytotoxin - leukocyte inhibition
Endotoxins
Exotoxins -A, S,
T - protein inhibition
Phospholipase C- hemolysin
Pili
Pyocyanin - tissue damage
Rhamnolipid- membrane damage
Biofilm
Pseudomonas aeruginosa will cause what in cows?
Mastitis, resp infections, uterine infections
What can Pseudomonas aeruginosa cause in dogs?
O. E, UTI, deep pyoderma
What will Pseudomonas aeruginosa cause in snakes?
Necrotic stomatitis (mouth rot)
What will Pseudomonas aeruginosa can in sows?
Mastitis -
Anorexia
Fever, edema in mammary region.
How do you tx Pseudomonas aeruginosa?
Fluoroquinolones, Gentamicin, Polymyxin B.
What will Pseudomonas aeruginosa smell like?
Fruity grapes/ corn tortillas.
Identify the pathogen?
Pseudomonas aeruginosa
Pseudomonas aeruginosa can be extremely __ to ABX and disinfectants?
resistant
Pseudomonas can be acquired in what settings?
Nosocomial (hospital settings)
vax for Pseudomonas exist for what animals?
Mink, chinchillas.